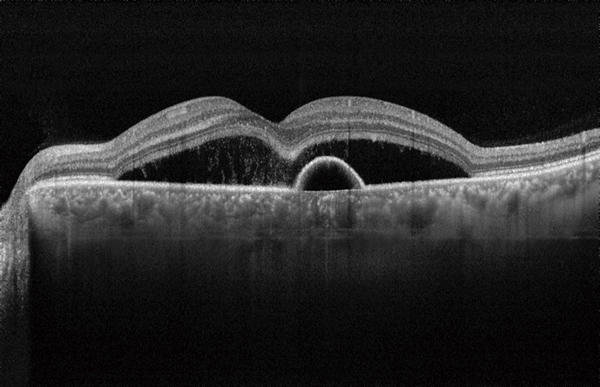
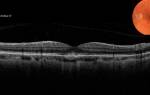

Долгое время ЦСХ считалась болезнью преимущественно молодых мужчин (25-45 лет). В последние годы в литературе появились сообщения об увеличении доли женщин и расширении возрастных рамок возникновения заболевания.
Классическая ЦСХ вызывается одной или несколькими точками просачивания через ПЭС обнаруживаемые при флюоресцентной ангиографии (ФAГ) как обширные площади гиперфлюоресценции. Однако в настоящее время известно, что ЦСХ может вызываться и диффузным просачиванием жидкости через ПЭС, что характеризуется отслойкой нейроэпителия сетчатки, лежащей над площадями атрофии ПЭС.
- При остром течении спонтанная абсорбция субретинальной жидкости происходит в течение 1-6 месяцев с восстановлением нормальной или близкой к норме остроты зрения.
- Подострое течение у некоторых пациентов ЦСХ продолжается более 6 месяцев, но спонтанно разрешается в течение 12 месяцев.
- Заболевание, протекающее более 12 месяцев относится к хроническому типу течения.
В современной офтальмологии центральную серозную хориоретинопатию принято разделять на две основные группы: острую (типичную) и хроническую (атипичную).
- Острая форма ЦСХ, как правило, развивается у молодых пациентов и имеет благоприятный прогноз, характеризуется идиопатической отслойкой нейроэпителия, связанной с появлением «активной точки фильтрации», которая, как правило, соответствует дефекту в ПЭ сетчатки. Через 3–6 месяцев после начала заболевания в 70–90% случаев происходит самостоятельное закрытие точек фильтрации, резорбции субретинальной жидкости и прилегание нейроэпителия сетчатки. Более длительный период может требоваться для восстановления остроты и качества зрения.
- Хроническая форма заболевания, как правило, развивается у пациентов старше 45 лет, чаще имеется двустороннее поражение, в основе которого лежит декомпенсация клеток ПЭ, сопровождающаяся развитием необратимых атрофических изменений в центральных отделах сетчатки и нарушением зрительных функций.
Этиопатогенез
Появление индоцианин зеленой ангиографии (ИЦЗА) выдвинуло на первый план важность состояния хориоидальной циркуляции в патогенезе ЦСХ. ИЦЗА продемонстрировала наличие многофокусной повышенной хориоидальной проницаемости и гипофлюоресценцию по площади, наводящие на размышления об очаговой хориоидальной сосудистой дисфункции. Некоторые исследователи полагают, что начальная хориоидальный сосудистая дисфункция впоследствии приводит к вторичной дисфункции прилежащего ПЭС.
Клинические исследования показывает наличие серозной отслойки сетчатки и пигментного эпителия и отсутствие при этом под сетчаткой крови. При отслойке пигментного эпителия может определяться локальные потери пигмента и его атрофия, фибрин, и иногда могут наблюдаться отложения липофусцина.
Конституция и системная гипертензия могут коррелировать с ЦСХ, по-видимому, из-за повышенного кортизола и адреналина в крови, которые воздействуют на ауторегуляцию хориоидальной гемодинамики. Кроме того, Tewari и другие установили, что пациенты с ЦСХ имеют снижение парасимпатической активности и значительное увеличение симпатической активности вегетативной нервной системы.
Исследование с помощью мультифокальной электроретинографии демонстрировали двустороннюю диффузную дисфункцию сетчатки, даже когда ЦСХ был активен только в одном глазу. Эти исследования показывают наличие системных изменений влияющих на них и поддерживают идею диффузного системного эффекта на хориоидальную васкуляризацию.
ЦСХ может быть проявлением системных изменений, которые возникают при трансплантации органов, экзогенном введении стероидов, эндогенном гиперкортицизме (синдром Кушинга), системной гипертензии, системной красная волчанке, беременности, желудочно-пищеводном рефлюксе, использовании виагры (sildenafil citrate), а также при использовании психофармакологических препаратов, антибиотиков и алкоголя.
Врачи отмечают, что центральная серозная хориоретинопатия представляет собой серьезное заболевание, которое требует внимательного подхода к диагностике и лечению. Это состояние чаще всего наблюдается у молодых мужчин и связано с повышенным уровнем стресса, а также с гормональными изменениями. Специалисты подчеркивают важность раннего выявления заболевания, так как это может предотвратить развитие серьезных осложнений, таких как атрофия сетчатки. Лечение может включать наблюдение, медикаментозную терапию и, в некоторых случаях, лазерную коагуляцию. Врачи также рекомендуют пациентам избегать стрессовых ситуаций и следить за своим психоэмоциональным состоянием, что может снизить риск рецидивов.

Диагностика

Подозрение на ЦСХ возникает при монокулярном затуманивании зрения, появлении метаморфопсий и диоптрийного синдрома (приобретенной гиперметропии). Острота зрения после коррекции положительными стеклами обычно 0,6-0,9.Даже при отсутствии указаний на наличие метаморфопсий, они легко обнаруживаются при исследовании с сеткой Амслера.
Тщательный расспрос обычно обнаруживает, что пациент чувствует себя более-менее комфортно только при средних уровнях освещенности — яркий свет вызывает чувство ослепления, а при сумеречном освещении он гораздо хуже видит из-за возникающего перед взором полупрозрачного пятна, При значительно выраженной микропсии возникают расстройства бинокулярного зрения, что вынуждает пациента сторониться некоторых занятий (например, вождения автомобиля). Нередко выявляется, что это не первый случай заболевания, и возник его рецидив при схожих условиях. Однако иногда заболевший человек, наоборот, не связывает заболевание с какими-то внешними обстоятельствами.
На глазном дне определяется пузырь серозной отслойки нейросенсорной сетчатки, расположенный в области макулы, имеющий четкие границы и обычно округлую форму. Его диаметр составляет 1-3 диаметра диска зрительного нерва. Помимо отслойки нейроэпителия часто выявляются дефекты пигментного слоя, отложения субретинального фибрина, липофусцина. Субретинальная жидкость прозрачна, нейросенсорная сетчатка не утолщена.Эта отслойка гораздо проще выявляется при офтальмоскопии с бескрасным фильтром, а ее границы четче видны (иногда буквально «вспыхивают») при офтальмоскопии с максимально диафрагмированным источником света. Объясняется такое свечение границ отслойки тем, что при незначительной глубине серозной полости свет проходит по ней, как по светопроводу, выходя в стекловидное тело на границе прилежащей сетчатки.
Диагноз ЦСХ нуждается в ангиографическом подтверждении. Особенно информативными являются ранние и отсроченные снимки. В типичных случаях наблюдается раннее появление точки фильтрации. Классическим описанием точки фильтрации является наличие фокуса гиперфлюоресценции в зоне серозной отслойки с восходящим от него током красителя в виде «столбика дыма». Между тем, на практике гораздо чаще встречается диффузия красителя в виде «чернильного пятна», концентрически распространяющаяся от точки фильтрации.
В ходе исследования флюоресцеин распределяется по всему объему пузыря. На отсроченных снимках отмечается диффузная гиперфлюоресиенция зоны отслойки. Исследование может обнаружить альтерации пигментного эпителия по соседству, свидетельствующие о ранее перенесенных обострениях ЦСХ, оставшихся незамеченными. Точка фильтрации чаще всего расположена в верхне-носовом квадрате от центра макулы. Литографическое исследование глазною дна с индоцианином у пациентов с ЦСХ часто выявляет зону начальной гипофлюоресценции, чуть превышающую в диаметре точку фильтрации. Эта начальная гипофлюоресценция быстро сменяется гиперфлюоресценцией в промежуточную и позднюю фазы исследования (между 1 и 10 минутами). Она объясняется повышенной проницаемостью хориокапилляров. Часто выявляются зоны гиперфлюоресценции, которые не видны на ангиографии с флюоресцеином. Таким образом, индоцианиновая ангиография подтверждает диффузный характер повреждения сосудов хориоидеи при центральной серозной хориопатии.
Оптическая когерентная томография (OCT) показывает различные виды патофизиологических изменений при ЦСХ, от появления субретинальной жидкости и отслойки пигментного эпителия до дистрофических изменений сетчатки при хронической форме течения заболевания. OCT особенно полезна в идентификации незначительных и даже субклинических отслоек сетчатки в макулярной зоне.
Дифференциальная диагностика
- Экссудативная форма ВМД.
- Макулярный отёк Ирвина-Гасса (Irvine-Gass).
- Макулярное отверстие.
- Субретинальная неоваскулярная мембрана.
- Хориоидальная неоваскуляризация.
- Хороидальная гемангиома
- Экссудативная отслойка сетчатки.
- Регматогенная отслойка сетчатки.
- Туберкулезный хориоидит
- Болезнь Фогта-Коянаги-Харада.
Центральная серозная хориоретинопатия (ЦСХ) вызывает много обсуждений среди пациентов и специалистов. Люди, столкнувшиеся с этой болезнью, часто описывают свои ощущения как внезапное ухудшение зрения, появление искажений и темных пятен. Многие отмечают, что стресс и эмоциональные нагрузки могут усугублять симптомы, что подтверждается множеством исследований. Пациенты делятся опытом лечения, включая использование лазерной терапии и медикаментов, однако результаты могут варьироваться. Важно, что многие находят поддержку в сообществах, где обмениваются советами и личными историями. Несмотря на сложности, оптимизм и надежда на восстановление зрения остаются важными аспектами в жизни людей с ЦСХ.
Лечение
В большинстве случаев ЦСХ проходит самостоятельно без всякого лечения (выжидательная тактика в течении 1-2 мес), локальная серозная отслойка бесследно исчезает, и зрение восстанавливается в былых пределах. Тем не менее, многие пациенты с достаточно хорошим зрением все же жалуются на искажение восприятия цветов или ощущение полупрозрачного пятна перед пораженным глазом. Объективизировать эти жалобы удается проверкой зрения с помощью визо-контрастометрических таблиц, по которым, в отличие от стандартных таблиц для проверки остроты зрения, все же удается обнаружить отличия в восприятии от нормы, в частности, в области высоких частот восприятия. Именно у этих лиц течение заболевания принимает хронический характер, или отличается частыми рецидивами серозной отслойки сетчатки. Пациенты с классической ЦСХР имеют риск рецидива около 40-50% в том же глазу.
Эффективность медикаментозного лечения оспаривается многими исследователями, однако, принимая во внимание особенности патогенеза, а именно наличие нейрогенного фактора, все же целесообразно назначение транквилизаторов.
Лазерное лечение
Решение о лазеркоагуляции сетчатки должно приниматься в следующих случаях:
- наличие серозной отслойки сетчатки в течение 4 месяцев и более;
- рецидив ЦСХР в глазу с имеющимся снижением остроты зрения после предыдущей ЦСХР;
- наличие снижения зрительных функций в парном глазу после ЦСХР в анамнезе;
- профессиональная или другая потребность для пациента, требующая быстрого восстановления зрения.
- Вопрос о лазерном лечении также может быть рассмотрен у пациентов с рецидивирующими эпизодами серозной отслойки с точкой просачивания флюоресцеина, расположенной на расстоянии более чем 300 µm от центра фовеа
При наличии одной или нескольких точек просачивания красителя по данным флюоресцентной ангиографии, расположенных далеко от фовеолярной аваскулярной зоны (ФАЗ), эффективным и относительно безопасным методом является надпороговая коагуляция сетчатки. Причем расстояние от аваскулярной зоны по данным различных авторов варьирует от 250 до 500 мкм. Для лечения используется лазерное излучение видимого диапазона на длине волны 0,532 мкм и ближнего инфракрасного диапазона на длине волны 0,810 мкм, т.к. именно их спектральные характеристики обеспечивают максимально щадящее воздействие на ткани глазного дна. Параметры излучения подбираются индивидуально, до появления очага коагуляции 1 типа по классификации L’Esperance. При использовании излучения на длине волны 0,532 мкм мощность варьирует от 0,07 до 0,16 Вт, длительность воздействия 0,07-0,1 с, диаметр пятна 100-200мкм. При использовании излучения на длине волны 0,810 мкм мощность варьирует от 0,35 до 1,2 Вт, длительность воздействия 0,2 с, диаметр пятна 125-200 мкм. Необходимо отметить, что многие исследователи считают, что риск повторения заболевания в коагулированных глазах меньше, чем в некоагулированных.
Несмотря на несомненную эффективность надпороговой коагуляции точек фильтрации, метод имеет ряд ограничений, нежелательных эффектов и осложнений, таких как атрофия пигментного эпителия, формирование субретинальной неоваскулярной мембраны (СНМ) и появление абсолютных скотом.
Расширение возможностей в лечении ЦСХ связано с широким применением в клинической практике микроимпульсных режимов лазерного излучения. Причем наиболее перспективно использование излучения диодного лазера на длине волны 0.81 мкм, спектральные характеристики которого обеспечивают его избирательное воздействие на микроструктуры хориоретинального комплекса.
В микроимпульсном режиме лазеры генерируют серию («пачки») повторяющихся низкоэнергетических импульсов сверхмалой длительности, коагуляционный эффект которых, суммируясь, вызывает повышение температуры только в ткани мишени, т.е. в пигментном эпителии. Благодаря этому в смежных структурах не достигается порог коагуляции, т.к. они успевают остыть, и это позволяет в большей степени минимизировать повреждающий эффект в отношении нейросенсорных клеток.
Таким образом, при наличии точек просачивания, расположенных суб- или юкстафовеолярно и, особенно на фоне атрофических изменений ПЭ, большинством исследователей применяется субпороговая микроимпульсная лазеркоагуляция сетчатки (СМИЛК) с использованием излучения диодного лазера на длине волны 0,81 мкм. После проведенных лазерных вмешательств, отмечено отсутствие осложнений, характерных для надпороговой коагуляции.
Существуют различные модификации СМИЛК . В последние годы альтернативным методом лечения хронической формы ЦСХ становится фотодинамическая терапия (ФДТ) с препаратом визудин. Данная методика, направленная на закрытие точки фильтрации вследствие дефекта ПЭ, может ускорить устранение экссудации за счет хориокапиллярной окклюзии и прекращения просачивания в этой зоне. После ФДТ наступает реконструирование хориоидальных сосудов и снижение их проницаемости. Положительный эффект ФДТ при лечении указанного заболевания получен многими исследователями. По данным различных авторов приблизительно у 85-90% пациентов происходит регресс отслойки нейроэпителия (ОНЭ) сетчатки, сохранение высокой остроты зрения в среднем 0,6-0,7. Препарат целесообразно использовать в половине стандартной дозы при лечении хронической ЦСХ, т.к. это позволяет избежать возможных осложнений (появление жалоб пациентов на увеличение пятна перед глазом, на ангиограммах в зонах воздействия выявлялись новые зоны атрофии ПЭ) с тем же уровнем эффективности, что достигается при использовании полной дозы.
В литературе имеются единичные сообщения о применении транспупиллярной терапии в лечении хронической формы ЦСХ. Авторы отмечали статистически достоверное (р<0,001) уменьшение ОНЭ и стабилизацию зрительных функций.
В отношении интравитреального введения ингибиторов эндотелиального сосудистого фактора роста (луцентис, авастин) в лечении ЦСХ на сегодняшний день однозначного мнения нет. В клинической практике ингибиторы ангиогенеза проявили себя не только как средства, подавляющие рост неососудов, но и продемонстрировали выраженный противоотечный эффект. Описаны случаи успешного применения авастина как при лечении острых, так и хронических форм заболевания.
Таким образом, на сегодняшний день лечение острой формы ЦСХ не вызывает затруднений. Если самостоятельного выздоровления не происходит, применяется традиционная лазеркоагуляция сетчатки или микроимпульсная, в зависимости от локализации точек фильтрации. В лечении хронической формы ЦСХ имеется несколько направлений: микроимпульсная лазеркоагуляция, изучаются перспективы использования фотодинамической терапии, транспупиллярной терапии и ингибиторов ангиогенеза.

Вопрос-ответ
Что такое центральная серозная хориоретинопатия?
Центральная серозная хориоретинопатия (ЦСХ) — это заболевание, при котором под сетчаткой накапливается жидкость, что может приводить к ухудшению зрения. Это состояние чаще всего наблюдается у мужчин в возрасте от 20 до 50 лет и может быть связано со стрессом, гормональными изменениями или приемом некоторых медикаментов.

Каковы основные симптомы ЦСХ?
Основные симптомы центральной серозной хориоретинопатии включают размытость или искажение зрения, появление темных пятен в поле зрения и затруднения при чтении. Пациенты могут также замечать, что цвета кажутся менее яркими или измененными.
Как лечится центральная серозная хориоретинопатия?
Лечение ЦСХ может варьироваться в зависимости от тяжести состояния. В большинстве случаев заболевание проходит самостоятельно в течение нескольких месяцев. Однако в некоторых случаях могут быть рекомендованы методы, такие как лазерная терапия или инъекции медикаментов, если симптомы не исчезают или ухудшаются.
Советы
СОВЕТ №1
Регулярно проходите обследования у офтальмолога, особенно если у вас есть предрасположенность к заболеваниям глаз. Раннее выявление ЦСХ может значительно улучшить прогноз и снизить риск осложнений.
СОВЕТ №2
Обратите внимание на свое психоэмоциональное состояние. Стресс и эмоциональное напряжение могут способствовать развитию ЦСХ, поэтому важно находить время для релаксации и занятий, которые помогают снизить уровень стресса.
СОВЕТ №3
Следите за своим образом жизни: сбалансированное питание, регулярные физические нагрузки и отказ от вредных привычек могут помочь укрепить общее здоровье и снизить риск развития заболеваний глаз.
СОВЕТ №4
Если вы заметили изменения в зрении, такие как размытость или искажение изображений, не откладывайте визит к врачу. Быстрое обращение за медицинской помощью может предотвратить серьезные последствия.